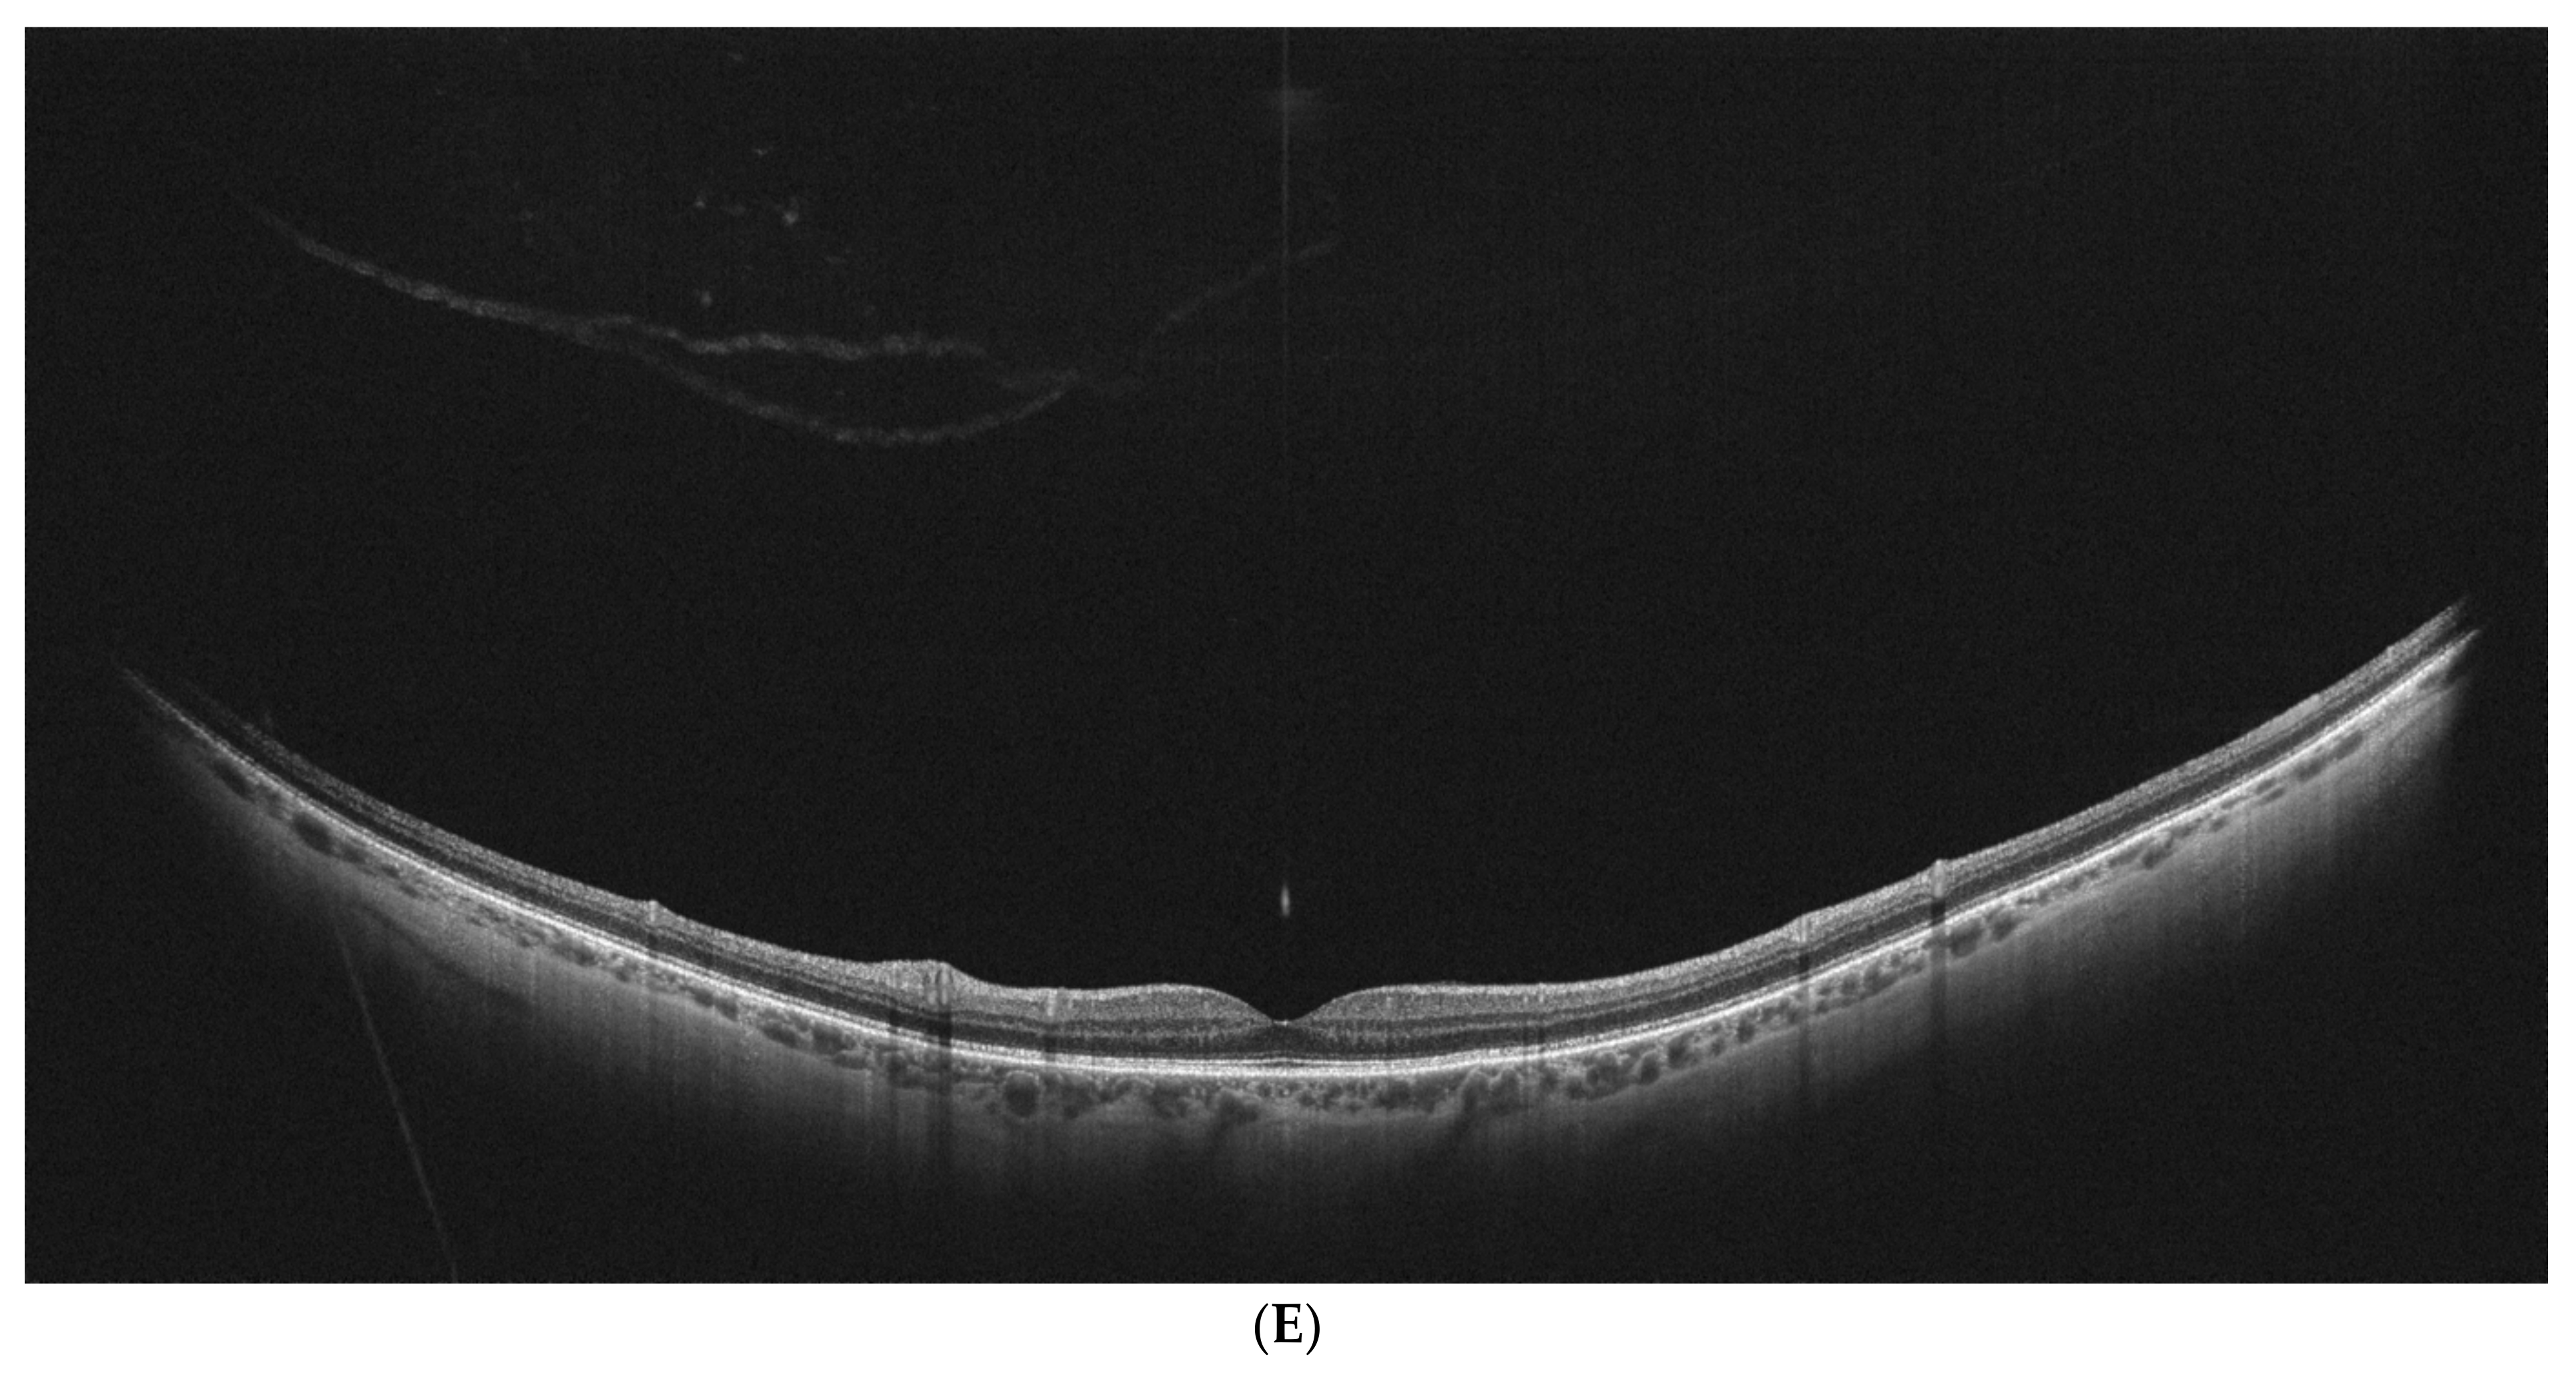
Diagnostics 15 01382 g002c

Posterior Vitreous Detachment in Healthy Versus AMD Eyes Assessed by Widefield Optical Coherence Tomography
Abstract
1. Introduction
2. Materials and Methods
3. Statistical Analysis
4. Results
5. Discussion
6. Study Limitations
7. Conclusions
Author Contributions
Funding
Institutional Review Board Statement
Informed Consent Statement
Data Availability Statement
Conflicts of Interest
References
- Kiciński, K.; Gawęcki, M. Choroidal and Retinal Thicknesses in Healthy Eyes Measured with Ultra-Wide-Field Optical Coherence Tomography. Diagnostics 2024, 14, 1114. [Google Scholar] [CrossRef] [PubMed]
- Gawęcki, M.; Kiciński, K. Advantages of the Utilization of Wide-Field OCT and Wide-Field OCT Angiography in Clinical Practice. Diagnostics 2024, 14, 321. [Google Scholar] [CrossRef] [PubMed]
- Stanga, P.E.; Pastor-Idoate, S.; Reinstein, U.; Vatas, P.; Patel, U.; Dubovy, S.; Reinstein, D.Z.; Zahavi, O. Navigated Single-capture 3D and Cross-sectional Wide-field OCT of the Mid and Peripheral Retina and Vitreoretinal Interface. Eur. J. Ophthalmol. 2022, 32, 1642–1651. [Google Scholar] [CrossRef] [PubMed]
- Kim, J.; Choi, K.S. Peripheral Lattice Degeneration Imaging with Ultra-Widefield Swept-Source Optical Coherence Tomography. Korean J. Ophthalmol. 2023, 37, 485–489. [Google Scholar] [CrossRef] [PubMed]
- Bleicher, I.D.; Garg, I.; Hoyek, S.; Place, E.; Miller, J.B.; Patel, N.A. Widefield Swept-Source Optical Coherence Tomography Angiography Findings in Wagner Syndrome. Retin. Cases Brief. Rep. 2024, 18, 80–86. [Google Scholar] [CrossRef] [PubMed]
- Tsukahara, M.; Mori, K.; Gehlbach, P.L.; Mori, K. Posterior Vitreous Detachment as Observed by Wide-Angle OCT Imaging. Ophthalmology 2018, 125, 1372–1383. [Google Scholar] [CrossRef] [PubMed]
- Ferris, F.L., 3rd; Wilkinson, C.P.; Bird, A.; Chakravarthy, U.; Chew, E.; Csaky, K.; Sadda, S.R.; Beckman Initiative for Macular Research Classification Committee. Clinical classification of age-related macular degeneration. Ophthalmology 2013, 120, 844–851. [Google Scholar] [CrossRef] [PubMed]
- Chiku, Y.; Hirano, T.; Takahashi, Y.; Tuchiya, A.; Nakamura, M.; Murata, T. Evaluating Posterior Vitreous Detachment by Widefield 23-mm Swept-source Optical Coherence Tomography Imaging in Healthy Subjects. Sci. Rep. 2021, 11, 19754. [Google Scholar] [CrossRef] [PubMed]
- Takahashi, H.; Nakao, N.; Shinohara, K.; Sugisawa, K.; Uramoto, K.; Igarashi-Yokoi, T.; Yoshida, T.; Ohno-Matsui, K. Posterior Vitreous Detachment and Paravascular Retinoschisis in Highly Myopic Young Patients Detected by Ultra-widefield OCT. Sci. Rep. 2021, 11, 17330. [Google Scholar] [CrossRef] [PubMed]
- Veloso, C.E.; Kanadani, T.M.; Pereira, F.B.; Nehemy, M.B. Vitreomacular Interface after Anti-Vascular Endothelial Growth Factor Injections in Neovascular Age-Related Macular Degeneration. Ophthalmology 2015, 122, 1569–1572. [Google Scholar] [CrossRef] [PubMed]
- Veloso, C.E.; Brocchi, D.N.; Singh, R.P.; Nehemy, M.B. Vitreomacular Interface After Anti-VEGF Injections in Diabetic Macular Edema. Int. J. Retin. Vitr. 2021, 7, 23. [Google Scholar] [CrossRef] [PubMed]
- Gattoussi, S.; Cougnard-Grégoire, A.; Delyfer, M.N.; Rougier, M.B.; Schweitzer, C.; Delcourt, C.; Korobelnik, J.F. Vitreomacular Adhesion and Its Association with Age-Related Macular Degeneration in a Population-Based Setting: The Alienor Study. Investig. Ophthalmol. Vis. Sci. 2017, 58, 2180–2186. [Google Scholar] [CrossRef] [PubMed]
- Jackson, T.L.; Nicod, E.; Angelis, A.; Grimaccia, F.; Prevost, A.T.; Simpson, A.R.; Kanavos, P. Vitreous Attachment in Age-related Macular Degeneration, Diabetic Macular Edema, and Retinal Vein Occlusion: A Systematic Review and Metaanalysis. Retina 2013, 33, 1099–1108. [Google Scholar] [CrossRef] [PubMed]
- Bakaliou, A.; Georgakopoulos, C.; Tsilimbaris, M.; Farmakakis, N. Posterior Vitreous Detachment and its Role in the Evolution of Dry to Wet Age Related Macular Degeneration. Clin. Ophthalmol. 2023, 17, 879–885. [Google Scholar] [CrossRef] [PubMed]
- Ilim, O.; Akkin, C.; Oztas, Z.; Nalcaci, S.; Afrashi, F.; Degirmenci, C.; Mentes, J. The Role of Posterior Vitreous Detachment and Vitreomacular Adhesion in Patients with Age-Related Macular Degeneration. Ophthalmic. Surg. Lasers Imaging Retin. 2017, 48, 223–229. [Google Scholar] [CrossRef] [PubMed]
- Maier, M.; Pfrommer, S.; Burzer, S.; Feucht, N.; Winkler von Mohrenfels, C.; Lohmann, C.P. Vitreomakuläre Grenzfläche und Posteriore Vitreomakuläre Adhäsion bei Exsudativer Altersabhängiger Makuladegeneration (AMD): Eine OCT-basierte Vergleichsstudie [Vitreomacular Interface and Posterior Vitreomacular Adhesion in Exudative Age-related Macular Degeneration (AMD): An OCT-based Comparative Study]. Klin. Monbl. Augenheilkd. 2012, 229, 1030–1035. [Google Scholar] [PubMed]
- Lee, S.J.; Lee, C.S.; Koh, H.J. Posterior Vitreomacular Adhesion and Risk of Exudative Age-related Macular Degeneration: Paired Eye Study. Am. J. Ophthalmol. 2009, 147, 621–626.e1. [Google Scholar] [PubMed]
- Kang, E.C.; Koh, H.J. Effects of Vitreomacular Adhesion on Age-Related Macular Degeneration. J. Ophthalmol. 2015, 2015, 865083. [Google Scholar] [CrossRef] [PubMed]

| Analyzed Trait | Controls | Wet AMD | Dry AMD | p Value |
|---|---|---|---|---|
| Number of participants, n (%) | 53 (23.77) | 87 (39.01) | 83 (37.22) | |
| Number of eyes, n (%) | 85 (25.68) | 123 (37.16) | 123 (37.16) | |
| Sex, n (%): | ||||
| 26 (49.06) | 58 (66.67) | 60 (72.29) | 0.0192 |
| 27 (50.94) | 29 (33.33) | 23 (27.71) | |
| Age (years) | 68.02 +/− 8.78 | 74.54 +/− 6.87 | 74.43 +/− 5.78 | <0.0001 |
| Axial length [mm] | 24.67 +/− 1.24 | 24.78 +/− 1.67 | 24.97 +/− 1.9 | 0.4174 |
| BCVA (logMAR) | 0.0 | 0.61 +/− 0.44 | 0.21 +/− 0.3 | <0.0001 |
| AMD stage, n (%): | ||||
| 1 | na | 0 (0.00) | 0 (0.00) | |
| 2 | na | 0 (0.00) | 21 (17.07) | |
| 3 | na | 0 (0.00) | 92 (74.80) | |
| 4 | na | 123 (100) | 10 (8.13) |
| (A) | ||||
|---|---|---|---|---|
| Analyzed Trait | Controls | Wet AMD | Dry AMD | p Value |
| PVD stage, n (%): | ||||
| 1a | 15 (17.65) | 2 (1.63) | 0 (0.00) | =0.0006 |
| 1b | 11 (12.94) | 8 (6.50) | 15 (12.20) | |
| 2 | 12 (14.12) | 21 (17.07) | 15 (12.20) | |
| 3 | 7 (8.23) | 26 (21.14) | 13 (10.57) | |
| 4 | 40 (47.06) | 66 (53.66) | 80 (65.03) | |
| (B) | ||||
| Controls | Wet AMD | Dry AMD | ||
| Controls | X | 0.0084 | 0.0006 | |
| Wet AMD | 0.0084 | X | 0.2180 | |
| Dry AMD | 0.0006 | 0.2180 | X | |
| PVD Stage | Number of IVI | p Value * | |||
|---|---|---|---|---|---|
| M | SD | Me | Q1–Q3 | ||
| 1 + 2 | 10.27 | 4.45 | 10.00 | 8.00–12.00 | =0.2634 |
| 3 + 4 | 9.42 | 5.71 | 8.00 | 5.00–13.00 | |
| (a) | ||||||
|---|---|---|---|---|---|---|
| BCVA logMAR | PVD Stage | Statistical Parameter * | p Value ** | |||
| M | SD | Me | Q1–Q3 | |||
| Wet AMD | 1a | 0.50 | 0.14 | 0.50 | 0.40–0.60 | =0.0078 |
| 1b | 1.09 | 0.64 | 0.85 | 0.65–1.50 | ||
| 2 | 0.51 | 0.34 | 0.40 | 0.30–0.70 | ||
| 3 | 0.61 | 0.49 | 0.40 | 0.30–0.70 | ||
| 4 | 0.59 | 0.41 | 0.50 | 0.30–0.70 | ||
| Dry AMD | 1a | n/d | n/d | n/d | n/d | =0.1925 |
| 1b | 0.31 | 0.33 | 0.25 | 0.05–0.50 | ||
| 2 | 0.17 | 0.19 | 0.10 | 0.10–0.20 | ||
| 3 | 0.22 | 0.39 | 0.10 | 0.00–0.25 | ||
| 4 | 0.20 | 0.30 | 0.10 | 0.00–0.20 | ||
| (b) | ||||||
| BCVAlog MAR | PVD Stage | Statistical Parameter * | p Value ** | |||
| M | SD | Me | Q1–Q3 | |||
| Wet AMD | 1 + 2 | 0.51 | 0.36 | 0.40 | 0.30–0.70 | =0.1844 |
| 3 + 4 | 0.65 | 0.46 | 0.60 | 0.30–0.70 | ||
| Dry AMD | 1 + 2 | 0.23 | 0.32 | 0.10 | 0.00–0.30 | =0.8190 |
| 3 + 4 | 0.21 | 0.30 | 0.10 | 0.10–0.20 | ||
| Central Retinal Thickness (µm) | PVD Stage | Statistical Parameter * | p Value ** | |||
|---|---|---|---|---|---|---|
| M | SD | Me | Q1–Q3 | |||
| Controls | 1a | 341.47 | 16.26 | 339.00 | 328.00–358.00 | =0.3353 |
| 1b | 331.64 | 14.14 | 334.00 | 323.00–341.00 | ||
| 2 | 344.58 | 20.60 | 350.00 | 333.00–357.50 | ||
| 3 | 323.43 | 16.29 | 332.00 | 305.00–334.00 | ||
| 4 | 331.77 | 24.72 | 332.00 | 322.00–346.50 | ||
| Wet AMD | 1a | 306.50 | 43.13 | 306.50 | 276.00–337.00 | =0.2532 |
| 1b | 346.50 | 64.06 | 331.50 | 294.50–399.50 | ||
| 2 | 331.33 | 48.08 | 320.00 | 303.00–340.00 | ||
| 3 | 343.04 | 62.99 | 330.00 | 305.00–368.00 | ||
| 4 | 319.24 | 50.82 | 310.00 | 285.00–351.00 | ||
| Dry AMD | 1a | n/d | n/d | n/d | n/d | =0.0534 |
| 1b | 320.73 | 27.16 | 321.00 | 302.00–351.00 | ||
| 2 | 318.47 | 24.79 | 325.00 | 295.00–341.00 | ||
| 3 | 322.46 | 21.52 | 325.00 | 305.00–345.00 | ||
| 4 | 329.51 | 19.67 | 330.00 | 317.00–342.50 | ||
| Perifoveal Retinal Thickness (µm) | PVD Stage | Statistical Parameter * | p Value ** | |||
|---|---|---|---|---|---|---|
| M | SD | Me | Q1–Q3 | |||
| Controls | 1a | 286.76 | 13.21 | 287.56 | 274.87–299.12 | =0.7389 |
| 1b | 289.12 | 9.51 | 289.44 | 281.69–296.62 | ||
| 2 | 291.05 | 13.72 | 289.62 | 281.25–297.97 | ||
| 3 | 278.33 | 12.51 | 279.00 | 263.75–219.19 | ||
| 4 | 284.18 | 15.98 | 281.87 | 275.87–296.69 | ||
| Wet AMD | 1a | 266.97 | 40.88 | 266.97 | 238.06–295.87 | =0.1323 |
| 1b | 267.60 | 40.71 | 269.94 | 231.87–283.56 | ||
| 2 | 278.04 | 18.45 | 281.06 | 263.06–288.94 | ||
| 3 | 289.16 | 36.17 | 288.84 | 257.75–302.37 | ||
| 4 | 275.59 | 25.16 | 273.37 | 260.56–295.25 | ||
| Dry AMD | 1a | na | na | na | na | =0.4205 |
| 1b | 282.35 | 16.68 | 280.69 | 270.06–299.00 | ||
| 2 | 281.27 | 15.75 | 279.62 | 273.81–291.06 | ||
| 3 | 285.55 | 15.62 | 282.50 | 272.75–289.00 | ||
| 4 | 286.47 | 15.28 | 284.16 | 276.31–295.47 | ||
| Peripheral Retinal Thickness (µm) | PVD Stage | Statistical Parameter * | p Value ** | |||
|---|---|---|---|---|---|---|
| M | SD | Me | Q1–Q3 | |||
| Controls | 1a | 220.91 | 8.78 | 223.75 | 211.87–226.12 | =0.1902 |
| 1b | 225.51 | 14.66 | 228.87 | 212.12–235.87 | ||
| 2 | 225.13 | 13.11 | 226.62 | 213.50–234.12 | ||
| 3 | 209.73 | 12.12 | 208.00 | 199.75–216.12 | ||
| 4 | 218.70 | 11.81 | 220.94 | 206.87–225.87 | ||
| Wet AMD | 1a | 217.81 | 32.97 | 217.81 | 194.50–241.12 | =0.2912 |
| 1b | 222.47 | 16.88 | 225.44 | 209.06–235.94 | ||
| 2 | 219.17 | 10.61 | 218.00 | 212.87–227.50 | ||
| 3 | 224.80 | 14.11 | 228.25 | 214.12–234.37 | ||
| 4 | 218.62 | 15.43 | 219.50 | 206.00–229.25 | ||
| Dry AMD | 1a | na | na | na | na | =0.4011 |
| 1b | 217.07 | 14.44 | 216.12 | 209.75–222.50 | ||
| 2 | 218.67 | 13.16 | 218.12 | 208.75–225.00 | ||
| 3 | 217.56 | 12.93 | 218.37 | 206.62–224.37 | ||
| 4 | 224.43 | 12.03 | 226.37 | 213.94–233.31 | ||
Disclaimer/Publisher’s Note: The statements, opinions and data contained in all publications are solely those of the individual author(s) and contributor(s) and not of MDPI and/or the editor(s). MDPI and/or the editor(s) disclaim responsibility for any injury to people or property resulting from any ideas, methods, instructions or products referred to in the content. |
© 2025 by the authors. Licensee MDPI, Basel, Switzerland. This article is an open access article distributed under the terms and conditions of the Creative Commons Attribution (CC BY) license (https://creativecommons.org/licenses/by/4.0/).
Share and Cite
Gawęcki, M.; Kiciński, K.; Grzybowski, A.; Teper, S. Posterior Vitreous Detachment in Healthy Versus AMD Eyes Assessed by Widefield Optical Coherence Tomography. Diagnostics 2025, 15, 1382. https://doi.org/10.3390/diagnostics15111382
Gawęcki M, Kiciński K, Grzybowski A, Teper S. Posterior Vitreous Detachment in Healthy Versus AMD Eyes Assessed by Widefield Optical Coherence Tomography. Diagnostics. 2025; 15(11):1382. https://doi.org/10.3390/diagnostics15111382
Chicago/Turabian StyleGawęcki, Maciej, Krzysztof Kiciński, Andrzej Grzybowski, and Sławomir Teper. 2025. "Posterior Vitreous Detachment in Healthy Versus AMD Eyes Assessed by Widefield Optical Coherence Tomography" Diagnostics 15, no. 11: 1382. https://doi.org/10.3390/diagnostics15111382
APA StyleGawęcki, M., Kiciński, K., Grzybowski, A., & Teper, S. (2025). Posterior Vitreous Detachment in Healthy Versus AMD Eyes Assessed by Widefield Optical Coherence Tomography. Diagnostics, 15(11), 1382. https://doi.org/10.3390/diagnostics15111382

